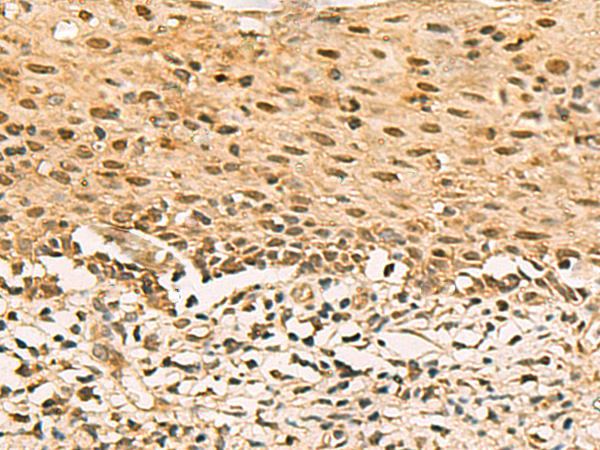
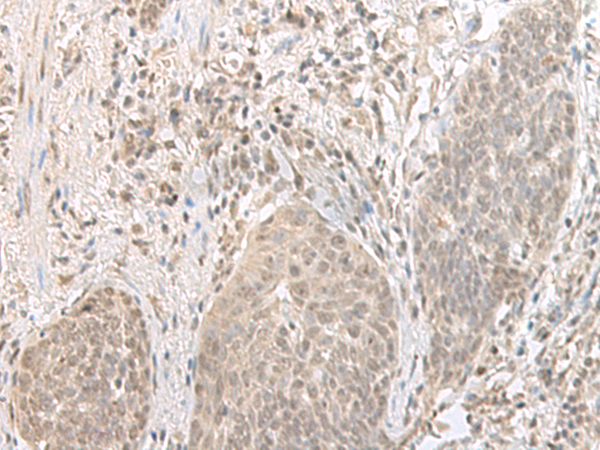

-
分类: 科研抗体货号: P09785别名: FXR2P; FMR1L2应用: WB,IHC反应种属: Human, Mouse
-
分类: 科研抗体货号: P09804别名: DJ122O8.2应用: IHC反应种属: Human, Mouse, Rat
-
分类: 科研抗体货号: P09784别名: 76P; GCP4; GCP-4; Grip76; MCCRP3应用: WB反应种属: Human, Mouse
-
分类: 科研抗体货号: P09803别名:应用: WB,IHC反应种属: Human, Mouse, Rat
-
分类: 科研抗体货号: P09783别名: Scml3应用: WB,IHC反应种属: Human, Mouse
-
分类: 科研抗体货号: P09802别名: DDP; MTS; DDP1; DFN1; TIM8应用: IHC反应种属: Human, Mouse, Rat
-
分类: 科研抗体货号: P09780别名: HSP70-2; HSP70-3应用: WB,IHC反应种属: Human, Mouse, Rat
-
分类: 科研抗体货号: P09801别名: ORC1L; PARC1; HSORC1应用: IHC反应种属: Human, Mouse, Rat
-
分类: 科研抗体货号: P09779别名: ASTML; ASMTLX; ASMTLY应用: IHC反应种属: Human
-
分类: 科研抗体货号: P09800别名: GASP2应用: IHC反应种属: Human, Mouse

鄂公网安备42018502007531号
鄂公网安备42018502007531号

